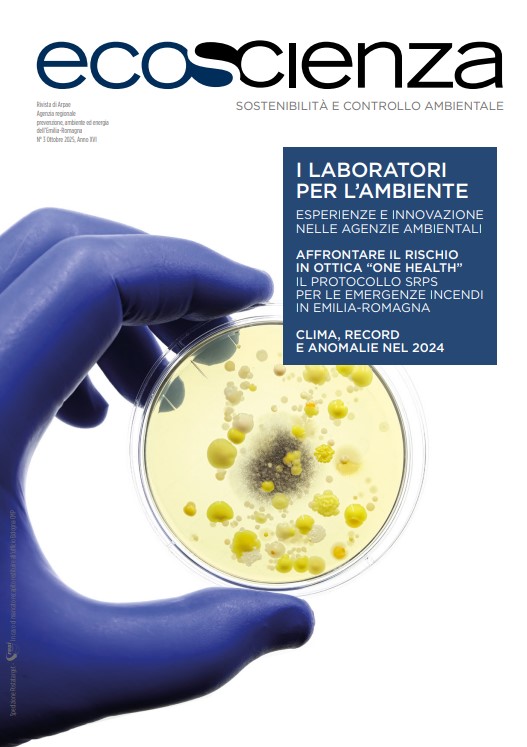
ecoscienza

Antimicrobicoresistenza, un tema chiave per ambiente e salute
Dai laboratori di Arpal ai tavoli di confronto nazionali, cresce l’impegno per affrontare l’antimicrobicoresistenza con un approccio integrato tra ambiente, salute e società.
Un impegno che attraversa ricerca, monitoraggio e prevenzione
L’antimicrobicoresistenza (AMR) è oggi una delle principali sfide globali per la salute pubblica.
Arpal affronta questo tema da una prospettiva ambientale, studiando la presenza di residui di antibiotici e di geni di resistenza nelle acque reflue e nei fanghi di depurazione, in linea con la nuova direttiva europea sulle acque urbane e con la visione One Health che unisce salute umana, animale e ambientale.
Il laboratorio di biologia molecolare di Arpal è al centro di queste attività e, nel numero 3/2025 della rivista Ecoscienza, viene presentato come esempio di integrazione tra sorveglianza ambientale e sanitaria.
Leggi l'articolo su Ecoscienza.
Un tema condiviso nel Sistema SNPA
L’antimicrobicoresistenza è stata anche al centro della tavola rotonda organizzata per i 30 anni di Arpal, dedicata al ruolo delle Agenzie ambientali nel sistema One Health e alle nuove frontiere della Planetary Health, che guarda alla salute del pianeta come condizione per la salute delle persone.
Su questi stessi temi, Rosella Bertolotto, Direttrice Dipartimento Stato dell’Ambiente e Tutela dai Rischi Naturali di Arpal , ha partecipato al Congresso nazionale SIFO, in un incontro dedicato agli impatti ambientali dei farmaci.
Accanto a lei erano presenti rappresentanti di Legambiente, dell’Istituto Zooprofilattico Sperimentale del Piemonte, Liguria e Valle d’Aosta, e del Dipartimento di Scienze Cliniche dell’Università di Torino, per discutere di come i residui farmaceutici influenzano gli ecosistemi e la fauna selvatica.
Ambiente e salute: una prospettiva integrata
Come indicato nel Piano Integrato di Attività e Organizzazione 2025–2027, Arpal è parte del Sistema Regionale Prevenzione Salute dai rischi ambientali e climatici (SRPS) e contribuisce, all’interno del SNPA, a sviluppare nuove capacità di monitoraggio per prevenire gli impatti ambientali sulla salute collettiva. Un impegno che passa dai monitoraggi, alle collaborazioni con enti di ricerca e alla comunicazione, per aumentare la consapevolezza pubblica su un tema che riguarda il futuro di tutti.